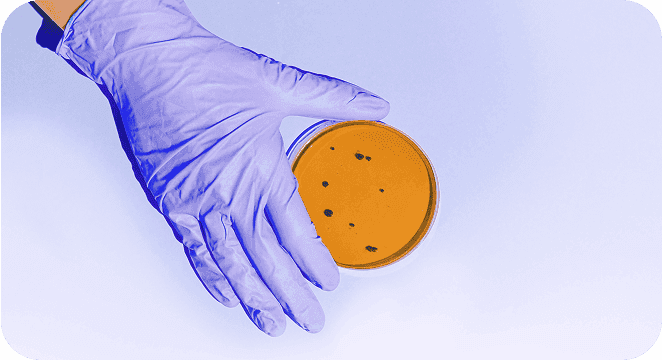

Konsultacijos
Vaizdo skambučiu arba žinutėmis, greičiau nei per 24 valandas.

Gydytojo konsultacija vaizdo skambučiu
34€
darbo dienomis
(8:00-18:00)
49€
savaitgaliais ir ne darbo metu
20 min. konsultacija – greičiau nei per 24 val.
Išsamus ir individualiai jums pritaikytas gydymo planas
E. receptai ir siuntimai per 2 val.
Nuodugni tyrimų rezultatų apžvalga
Pagalba ir vakarais, savaitgaliais bei švenčių dienomis
Nemokamos žinutės gydytojui (5 dienas po konsultacijos)

Gydytojo konsultacija žinutėmis
29€
Konsultacijos teikiamos
7:00-22:00 laiku
7:00-22:00 laiku
Bendraukite su gydytoju žinutėmis 2 dienas
Žinučių kiekis neribojamas
Gydytojo atsakymai per 2 val. darbo metu
Išsamus ir individualiai jums pritaikytas gydymo planas
E. receptai ir siuntimai per 2 val.
Nuodugni tyrimų rezultatų apžvalga
Papildomos paslaugos

E. receptai
19€
Vienam medikamentui.
E. receptus išrašome ir kompensuojamiems, ir nekompensuojamiems vaistams.
Receptą darbo metu ( 7:00–22:00), gaukite greičiau nei per 2 val.
Gydytojo išrašyti e. receptai iš karto matomi e. sveikatos platformoje.
Jei e. recepto reikiamiems vaistams išrašyti negalime, pinigus į jūsų sąskaitą grąžiname per artimiausias 48 val.

Tyrimų pakomentavimas
19€
Anksčiau atliktų (paskirtų ne uhealth gydytojo) laboratorinių tyrimų rezultatų pakomentavimas.
Tyrimai peržiūrimi per 1–2 valandas darbo metu (07:00 - 22:00).
Prireikus, gydytojas gali skirti papildomus tyrimus, išrašyti e. receptą ar siuntimą pas specialistą.

Laboratoriniai tyrimai
Nuo
5€
Tyrimai užsakomi tik konsultacijų metu.
Galimybė atlikti daugiau nei 100 skirtingų laboratorinių tyrimų.
Tyrimai atliekami mūsų partnerių laboratorijose visoje Lietuvoje arba jūsų pasirinktoje įstaigoje.
Jei siuntimą tyrimams išrašo uhealth gydytojas, išsamus tyrimų aptarimas – visiškai nemokamas.
Dažniausiai užduodami klausimai
Tiesiogiai apmokėti uhealth sąskaitas draudimo kortele šiuo metu gali tik ERGO ir Gjensidige klientai. Jei esate kitos draudimo bendrovės klientas, patirtas išlaidas galite susigrąžinti savo draudimo bendrovei pateikdami mūsų išrašytą sąskaitą-faktūrą įprasta tvarka.